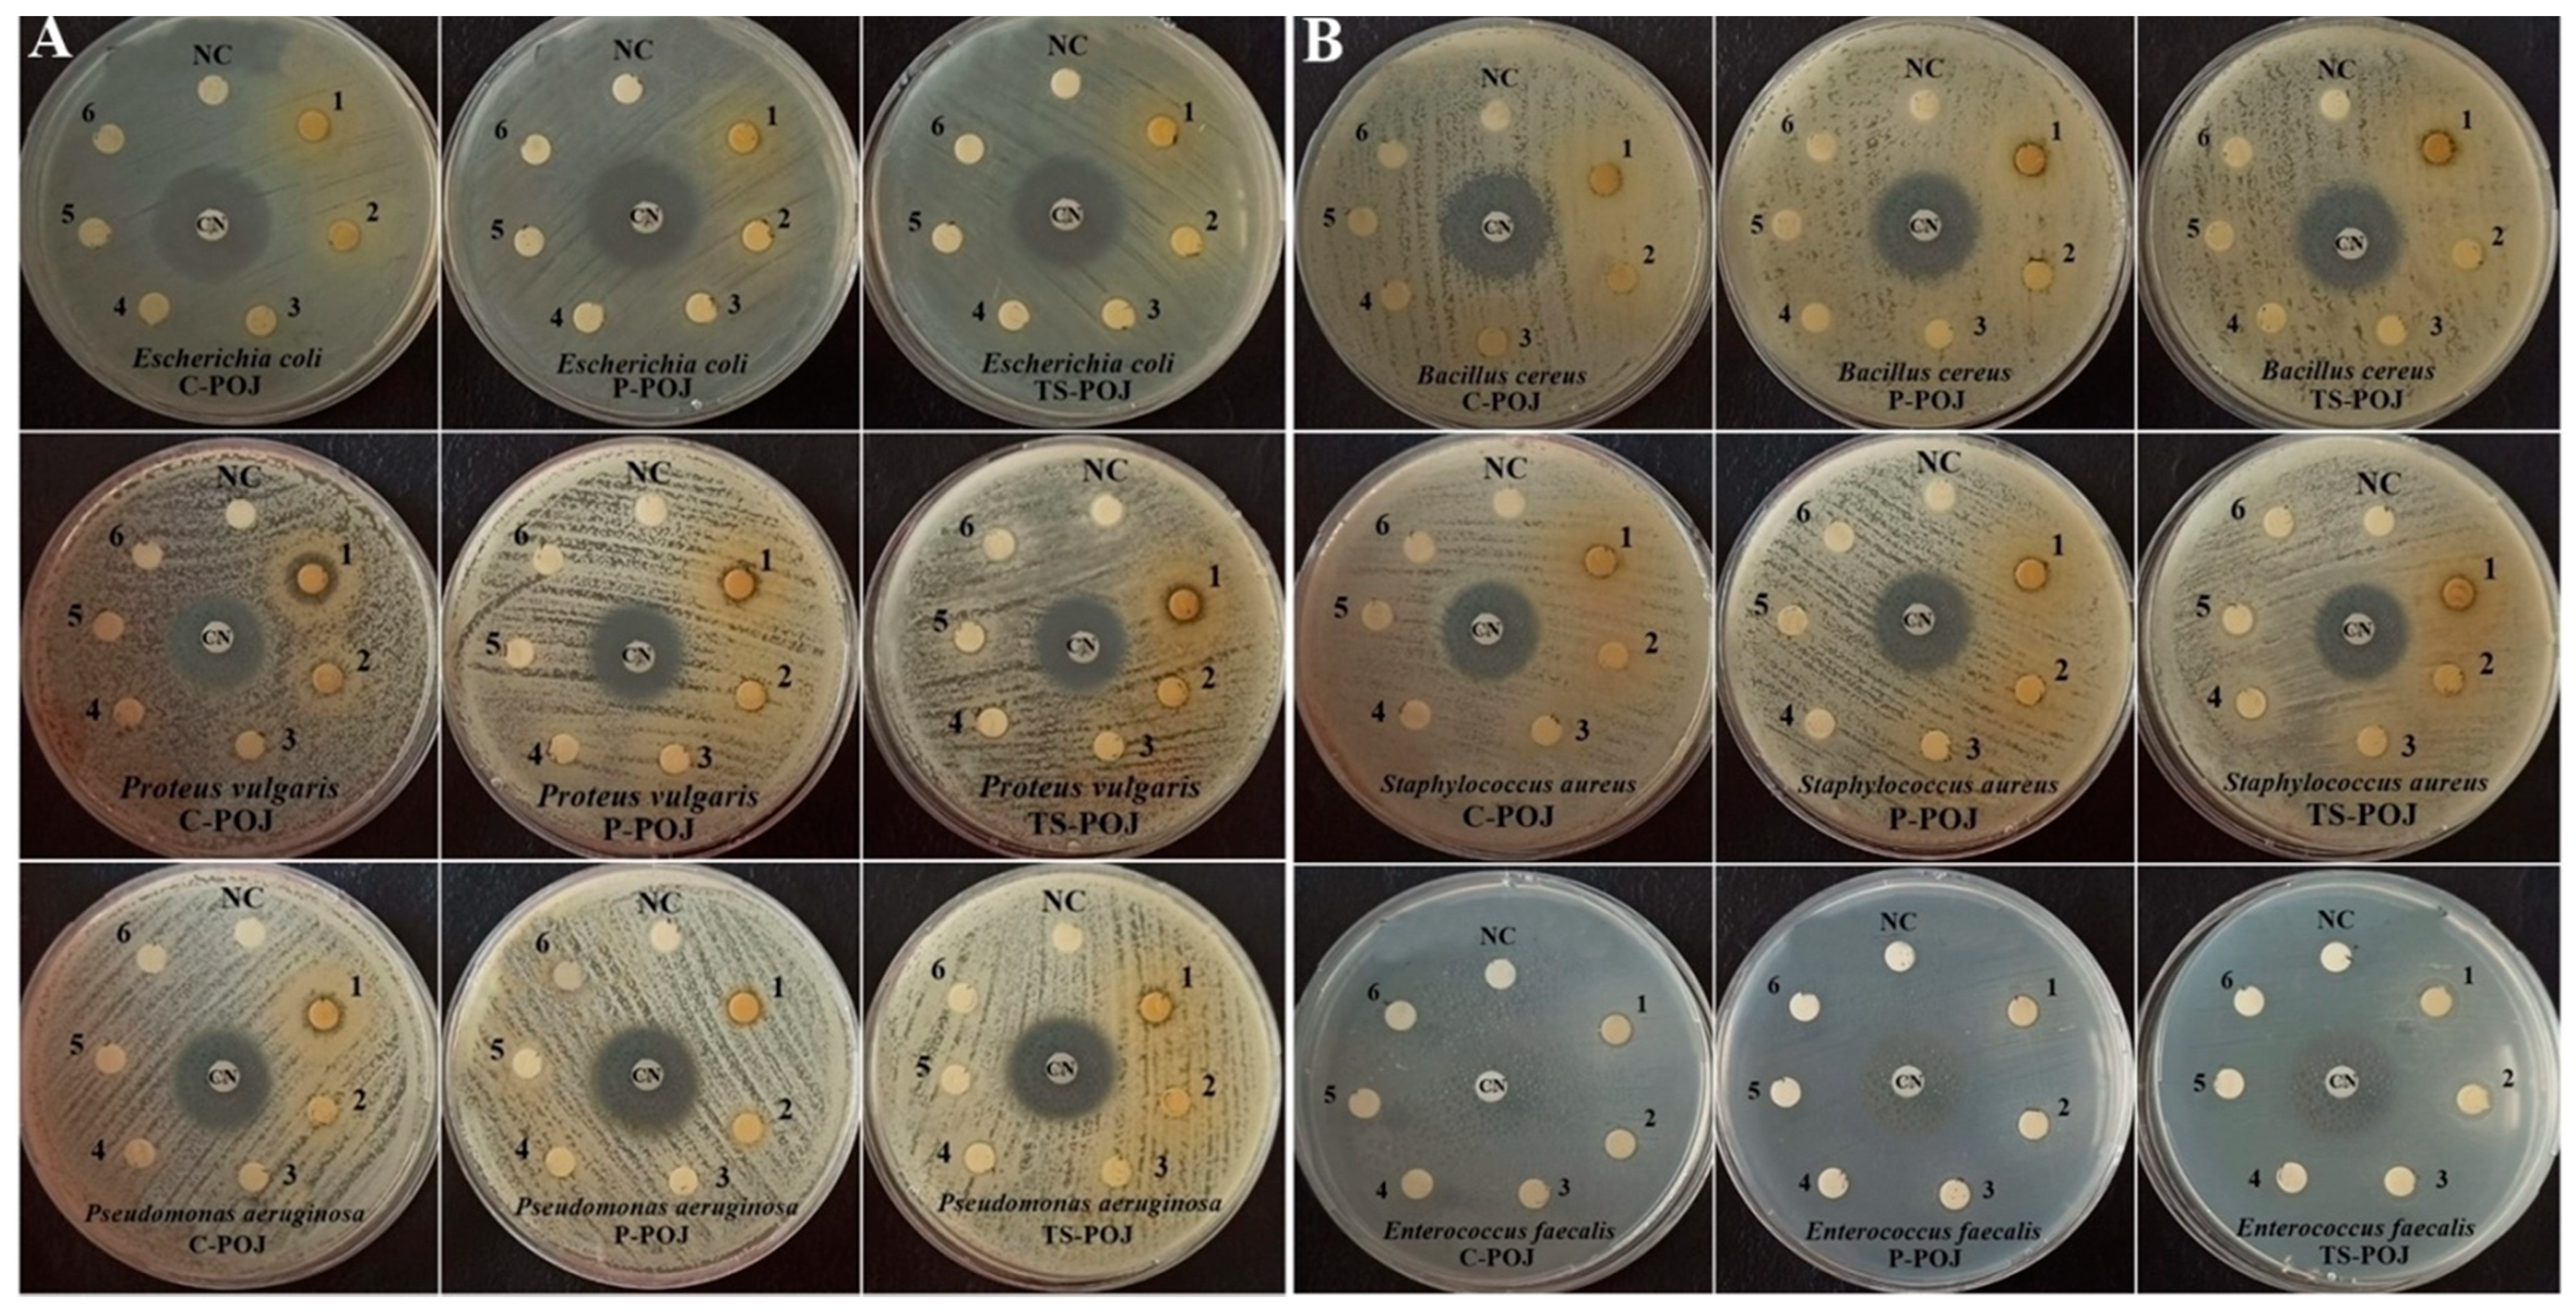

Thermosonication Processing of Purple Onion Juice (Allium cepa L.): Anticancer, Antibacterial, Antihypertensive, and Antidiabetic Effects
Abstract
1. Introduction
2. Materials and Methods
2.1. Purple Onion Juice Processing
2.2. Thermal Pasteurization and Thermosonication Treatments
2.3. Modelling Procedure for Response
2.4. Determination of Bioactive Compounds
2.5. Anticancer Activity
2.6. Antibacterial Activity
2.7. Angiotensin-Converting Enzyme (ACE) Inhibitory and Antidiabetic Effects
2.8. Determination of Ascorbic Acid
2.9. Statistical Analysis
3. Results
3.1. Optimization of TPC, TFC, DPPH, CUPRAC, and TAC Assays/Determinations
3.2. Anticancer Effects
3.3. Antibacterial Effects
3.4. ACE Inhibitory and Antidiabetic Activities
3.5. Ascorbic Acid Activities
4. Conclusions
Author Contributions
Funding
Data Availability Statement
Acknowledgments
Conflicts of Interest
References
- Bendaali, Y.; Vaquero, C.; González, C.; Morata, A. Elaboration of an organic beverage based on grape juice with positive nutritional properties. Food Sci. Nutr. 2022, 10, 1768–1779. [Google Scholar] [CrossRef] [PubMed]
- Silva, E.K.; Meireles, M.A.A.; Saldaña, M.D.A. Supercritical carbon dioxide technology: A promising technique for the non-thermal processing of freshly fruit and vegetable juices. Trends Food Sci. Technol. 2020, 97, 381–390. [Google Scholar] [CrossRef]
- Zhao, X.-X.; Lin, F.-J.; Li, H.; Li, H.-B.; Wu, D.-T.; Geng, F.; Ma, W.; Wang, Y.; Miao, B.-H.; Gan, R.-Y. Recent Advances in Bioactive Compounds, Health Functions, and Safety Concerns of Onion (Allium cepa L.). Front. Nutr. 2021, 8, 669805. [Google Scholar] [CrossRef] [PubMed]
- Shabir, I.; Pandey, V.K.; Dar, A.H.; Pandiselvam, R.; Manzoor, S.; Mir, S.A.; Shams, R.; Dash, K.K.; Fayaz, U.; Khan, S.A.; et al. Nutritional Profile, Phytochemical Compounds, Biological Activities, and Utilisation of Onion Peel for Food Applications: A Review. Sustainability 2022, 14, 11958. [Google Scholar] [CrossRef]
- Urango, A.C.M.; Strieder, M.M.; Silva, E.K.; Meireles, M.A.A. Impact of Thermosonication Processing on Food Quality and Safety: A Review. Food Bioprocess Technol. 2022, 15, 1700–1728. [Google Scholar] [CrossRef]
- Hasheminya, S.M.; Dehghannya, J. Non-thermal processing of black carrot juice using ultrasound: Intensification of bioactive compounds and microbiological quality. Int. J. Food Sci. Technol. 2022, 57, 5848–5858. [Google Scholar] [CrossRef]
- Yıkmış, S.; Ozer, H.; Levent, O.; Çöl, B.G.; Erdal, B.; Yıkmış, S. Effect of thermosonication and thermal treatments on antidiabetic, antihypertensive, mineral elements and in vitro bioaccessibility of bioactive compounds in freshly squeezed pomegranate juice. J. Food Meas. Charact. 2022, 16, 3023–3041. [Google Scholar] [CrossRef]
- Çöl, B.G.; Akhan, M.; Sancar, B.Ç.; Türkol, M.; Yıkmış, S.; Hecer, C. Effect of Thermosonication on Amino Acids, Phenolic Compounds, Sensory Properties and Microbial Quality in Freshly Squeezed Verjuice. Foods 2023, 12, 2167. [Google Scholar] [CrossRef]
- Das, P.S.; Nayak, P.K.; Senthilnathan, K.; Das, P.; Kesavan, R. krishnan Optimization of thermosonication treatments to improve the quality parameters of posotia (Vitex negundo) juice. J. Agric. Food Res. 2023, 14, 100811. [Google Scholar] [CrossRef]
- Ramírez-Melo, L.M.; Cruz-Cansino, N.d.S.; Delgado-Olivares, L.; Ramírez-Moreno, E.; Zafra-Rojas, Q.Y.; Hernández-Traspeña, J.L.; Suárez-Jacobo, Á. Optimization of antioxidant activity properties of a thermosonicated beetroot (Beta vulgaris L.) juice and further in vitro bioaccessibility comparison with thermal treatments. LWT 2022, 154, 112780. [Google Scholar] [CrossRef]
- Kashyap, P.; Riar, C.S.; Jindal, N. Optimization of ultrasound assisted extraction of polyphenols from Meghalayan cherry fruit (Prunus nepalensis) using response surface methodology (RSM) and artificial neural network (ANN) approach. J. Food Meas. Charact. 2021, 15, 119–133. [Google Scholar] [CrossRef]
- Yu, H.C.; Huang, S.M.; Lin, W.M.; Kuo, C.H.; Shieh, C.J. Comparison of Artificial Neural Networks and Response Surface Methodology towards an Efficient Ultrasound-Assisted Extraction of Chlorogenic Acid from Lonicera japonica. Molecules 2019, 24, 2304. [Google Scholar] [CrossRef] [PubMed]
- Yıkmış, S.; Bozgeyik, E.; Levent, O.; Aksu, H. Organic cherry laurel (Prunus laurocerasus) vinegar enriched with bioactive compounds with ultrasound technology using artificial neural network (ANN) and response surface methodology (RSM): Antidiabetic, antihypertensive, cytotoxic activities, volatile profile and optical microstructure. J. Food Process. Preserv. 2021, 45, e15883. [Google Scholar] [CrossRef]
- Singleton, V.L.; Rossi, J.A. Colorimetry of Total Phenolics with Phosphomolybdic-Phosphotungstic Acid Reagents. Am. J. Enol. Vitic. 1965, 16, 144–158. [Google Scholar] [CrossRef]
- Zhishen, J.; Mengcheng, T.; Jianming, W. The determination of flavonoid contents in mulberry and their scavenging effects on superoxide radicals. Food Chem. 1999, 64, 555–559. [Google Scholar] [CrossRef]
- Giusti, M.; Wrolstad, R. Characterization and Measurement of Anthocyanins by UV-Visible Spectroscopy. In Current Protocols in Food Analytical Chemistry; John Wiley & Sons, Inc.: Hoboken, NJ, USA, 2001. [Google Scholar]
- Cemeroğlu, B. Gıda Analizleri, 2nd ed.; Nobel Yayıncılık: Ankara, Turkey, 2010. [Google Scholar]
- Grajeda-Iglesias, C.; Salas, E.; Barouh, N.; Baréa, B.; Panya, A.; Figueroa-Espinoza, M.C. Antioxidant activity of protocatechuates evaluated by DPPH, ORAC, and CAT methods. Food Chem. 2016, 194, 749–757. [Google Scholar] [CrossRef] [PubMed]
- Apak, R.; Güçlü, K.; Özyürek, M.; Esin Karademir, S.; Erçağ, E. The cupric ion reducing antioxidant capacity and polyphenolic content of some herbal teas. Int. J. Food Sci. Nutr. 2006, 57, 292–304. [Google Scholar] [CrossRef] [PubMed]
- Yıkmış, S.; Bozgeyik, E.; Şimşek, M.A. Ultrasound processing of verjuice (unripe grape juice) vinegar: Effect on bioactive compounds, sensory properties, microbiological quality and anticarcinogenic activity. J. Food Sci. Technol. 2020, 57, 3445–3456. [Google Scholar] [CrossRef]
- Wayne, P. CLSI. Performance Standards for Antimicrobial Susceptibility Testing, M100, 29th ed.; Clinical and Laboratory Standards Institute: Wayne, PA, USA, 2019. [Google Scholar]
- Cushman, D.W.; Cheung, H.S. Spectrophotometric assay and properties of the angiotensin-converting enzyme of rabbit lung. Biochem. Pharmacol. 1971, 20, 1637–1648. [Google Scholar] [CrossRef]
- Worthington, V. Enzyme Manual | Worthington Biochemical. In Alpha Amylase; Wohington Biochemical Company: Lakewood, NJ, USA, 1993; pp. 36–41. [Google Scholar]
- AOAC Association of Official Analytical Chemists. Official Methods of Analysis; AOAC: Washington, DC, USA, 1990. [Google Scholar]
- Gadioli Tarone, A.; Keven Silva, E.; Dias de Freitas Queiroz Barros, H.; Baú Betim Cazarin, C.; Roberto Marostica Junior, M. High-intensity ultrasound-assisted recovery of anthocyanins from jabuticaba by-products using green solvents: Effects of ultrasound intensity and solvent composition on the extraction of phenolic compounds. Food Res. Int. 2021, 140, 110048. [Google Scholar] [CrossRef]
- Kaur, B.; Panesar, P.S.; Anal, A.K. Standardization of ultrasound assisted extraction for the recovery of phenolic compounds from mango peels. J. Food Sci. Technol. 2022, 59, 2813–2820. [Google Scholar] [CrossRef]
- Li, W.; Gong, P.; Ma, H.; Xie, R.; Wei, J.; Xu, M. Ultrasound treatment degrades, changes the color, and improves the antioxidant activity of the anthocyanins in red radish. LWT 2022, 165, 113761. [Google Scholar] [CrossRef]
- Zhou, Y.; Li, C.; Feng, B.; Chen, B.; Jin, L.; Shen, Y. UPLC-ESI-MS/MS based identification and antioxidant, antibacterial, cytotoxic activities of aqueous extracts from storey onion (Allium cepa L. var. proliferum Regel). Food Res. Int. 2020, 130, 108969. [Google Scholar] [CrossRef]
- Yıkmış, S.; Erdal, B.; Bozgeyik, E.; Levent, O.; Yinanç, A. Evaluation of purple onion waste from the perspective of sustainability in gastronomy: Ultrasound-treated vinegar. Int. J. Gastron. Food Sci. 2022, 29, 100574. [Google Scholar] [CrossRef]
- Nile, A.; Gansukh, E.; Park, G.S.; Kim, D.H.; Hariram Nile, S. Novel insights on the multi-functional properties of flavonol glucosides from red onion (Allium cepa L) solid waste—In Vitro and in silico approach. Food Chem. 2021, 335, 127650. [Google Scholar] [CrossRef] [PubMed]
- Kim, J.; Kim, J.S.; Park, E. Cytotoxic and anti-inflammatory effects of onion peel extract on lipopolysaccharide stimulated human colon carcinoma cells. Food Chem. Toxicol. 2013, 62, 199–204. [Google Scholar] [CrossRef] [PubMed]
- Choe, S.; Siah, P.; Lim, S.; Peh, K.; Ong, M.; Khoo, B. The Cellular Activities of the Subfraction of Red Onion Peel Crude Ethanolic Extract in MDA-MB-231 Cells. Pharmacogn. Res. 2020, 12, 423. [Google Scholar] [CrossRef]
- Nausch, B.; Bittner, C.B.; Höller, M.; Abramov-Sommariva, D.; Hiergeist, A.; Gessner, A. Contribution of Symptomatic, Herbal Treatment Options to Antibiotic Stewardship and Microbiotic Health. Antibiotics 2022, 11, 1331. [Google Scholar] [CrossRef] [PubMed]
- Mnayer, D.; Fabiano-Tixier, A.S.; Petitcolas, E.; Hamieh, T.; Nehme, N.; Ferrant, C.; Fernandez, X.; Chemat, F. Chemical Composition, Antibacterial and Antioxidant Activities of Six Essentials Oils from the Alliaceae Family. Molecules 2014, 19, 20034–20053. [Google Scholar] [CrossRef] [PubMed]
- Ma, Y.L.; Zhu, D.Y.; Thakur, K.; Wang, C.H.; Wang, H.; Ren, Y.F.; Zhang, J.G.; Wei, Z.J. Antioxidant and antibacterial evaluation of polysaccharides sequentially extracted from onion (Allium cepa L.). Int. J. Biol. Macromol. 2018, 111, 92–101. [Google Scholar] [CrossRef] [PubMed]
- Putsakum, G.; Tzima, K.; Tiwari, B.K.; O’Donnell, C.P.; Rai, D.K. Effects of thermosonication on ascorbic acid, polyphenols and antioxidant activity in blackberry juice. Int. J. Food Sci. Technol. 2023, 58, 2304–2311. [Google Scholar] [CrossRef]
- Wurlitzer, N.J.; Dionísio, A.P.; Lima, J.R.; Garruti, D.d.S.; da Silva Araújo, I.M.; da Rocha, R.F.J.; Maia, J.L. Tropical fruit juice: Effect of thermal treatment and storage time on sensory and functional properties. J. Food Sci. Technol. 2019, 56, 5184–5193. [Google Scholar] [CrossRef] [PubMed]
- Sahu, R.K.; Minj, S.K.; Sahu, P. Thermosonication an Alternative to Thermal Pasteurization for Nagpur Mandarin Juice. Int. J. Plant Soil Sci. 2023, 35, 1181–1190. [Google Scholar] [CrossRef]

| Run No | Independent Variables | Dependent Variables | ||||||||||||||||
|---|---|---|---|---|---|---|---|---|---|---|---|---|---|---|---|---|---|---|
| Tempature (°C-X1) | Time (min-X2) | Amplitude (%-X3) | TPC (mg GAE/100 mL) | TFC (mg CE/100 mL) | DPPH (% Inhibition) | CUPRAC (% Inhibition) | TAC (mg of mv-3-glu/L) | |||||||||||
| Experimental Data | RSM Prediction | ANN Prediction | Experimental Data | RSM Prediction | ANN Prediction | Experimental Data | RSM Prediction | ANN Prediction | Experimental Data | RSM Prediction | ANN Prediction | Experimental Data | RSM Prediction | ANN Prediction | ||||
| 1 | 50 | 16 | 80 | 152.26 ± 1.95 | 152.24 | 153.12 | 20.85 ± 1.03 | 20.94 | 20.85 | 53.37 ± 0.54 | 53.95 | 53.37 | 56.28 ± 0.66 | 56.38 | 56.87 | 12.57 ± 0.20 | 12.93 | 12.57 |
| 2 | 50 | 12 | 80 | 160.14 ± 1.71 | 160.08 | 160.36 | 17.85 ± 0.54 | 17.88 | 17.85 | 44.63 ± 0.71 | 45.08 | 44.63 | 46.70 ± 0.81 | 46.88 | 46.71 | 10.31 ± 0.79 | 10.46 | 10.31 |
| 3 | 45 | 10 | 90 | 153.83 ± 0.55 | 154.29 | 153.90 | 21.98 ± 0.79 | 21.79 | 21.98 | 54.92 ± 0.42 | 54.60 | 54.92 | 57.15 ± 0.10 | 56.81 | 57.13 | 11.70 ± 0.65 | 11.68 | 11.59 |
| 4 | 50 | 12 | 100 | 147.74 ± 1.95 | 147.57 | 147.83 | 21.11 ± 1.51 | 21.23 | 21.11 | 49.20 ± 1.36 | 50.11 | 49.20 | 54.88 ± 0.40 | 55.17 | 55.01 | 12.19 ± 0.51 | 12.32 | 12.19 |
| 5 | 50 | 12 | 80 | 160.80 ± 1.22 | 160.08 | 160.36 | 17.85 ± 1.13 | 17.88 | 17.85 | 44.63 ± 0.72 | 45.08 | 44.63 | 46.70 ± 0.59 | 46.88 | 46.71 | 10.31 ± 0.13 | 10.46 | 10.31 |
| 6 | 55 | 14 | 90 | 156.13 ± 2.14 | 156.24 | 156.22 | 22.30 ± 0.41 | 21.91 | 22.30 | 52.94 ± 0.86 | 52.17 | 52.94 | 55.66 ± 1.27 | 55.24 | 55.66 | 12.89 ± 0.64 | 12.74 | 12.89 |
| 7 | 45 | 10 | 90 | 153.95 ± 2.60 | 154.29 | 153.90 | 21.99 ± 1.07 | 21.79 | 21.98 | 54.98 ± 0.34 | 54.60 | 54.92 | 57.22 ± 0.37 | 56.81 | 57.13 | 11.48 ± 0.37 | 11.68 | 11.59 |
| 8 | 50 | 12 | 80 | 160.14 ± 1.68 | 160.08 | 160.36 | 17.85 ± 0.28 | 17.88 | 17.85 | 44.63 ± 0.62 | 45.08 | 44.63 | 46.70 ± 1.15 | 46.88 | 46.71 | 10.31 ± 0.24 | 10.46 | 10.31 |
| 9 | 50 | 12 | 80 | 160.14 ± 1.53 | 160.08 | 160.36 | 17.85 ± 0.40 | 17.88 | 17.85 | 44.63 ± 0.57 | 45.08 | 44.63 | 46.70 ± 0.66 | 46.88 | 46.71 | 10.31 ± 0.44 | 10.46 | 10.31 |
| 10 | 55 | 14 | 70 | 147.36 ± 2.12 | 147.30 | 147.37 | 21.05 ± 1.80 | 20.84 | 21.05 | 52.63 ± 0.72 | 52.71 | 52.63 | 54.74 ± 0.85 | 54.32 | 54.66 | 12.16 ± 0.10 | 12.07 | 12.15 |
| 11 | 50 | 8 | 80 | 145.43 ± 1.34 | 144.54 | 145.11 | 19.68 ± 0.31 | 19.95 | 19.68 | 53.85 ± 0.89 | 55.07 | 53.85 | 56.27 ± 0.21 | 57.29 | 56.08 | 12.00 ± 0.62 | 12.10 | 12.02 |
| 12 | 50 | 12 | 80 | 160.14 ± 2.59 | 160.08 | 160.36 | 17.85 ± 0.74 | 17.88 | 17.85 | 44.63 ± 0.33 | 45.08 | 44.63 | 46.70 ± 0.34 | 46.88 | 46.71 | 10.31 ± 0.16 | 10.46 | 10.31 |
| 13 | 60 | 12 | 80 | 141.04 ± 1.36 | 140.91 | 140.82 | 20.15 ± 0.52 | 20.42 | 20.15 | 51.44 ± 1.02 | 52.54 | 51.44 | 53.39 ± 0.47 | 54.10 | 53.27 | 11.94 ± 0.92 | 12.27 | 11.94 |
| 14 | 45 | 10 | 70 | 149.62 ± 3.38 | 150.29 | 149.66 | 21.37 ± 0.88 | 21.20 | 21.37 | 53.28 ± 0.35 | 53.19 | 53.28 | 55.57 ± 0.47 | 54.84 | 55.52 | 12.48 ± 0.21 | 12.59 | 12.46 |
| 15 | 50 | 12 | 60 | 135.37 ± 1.10 | 134.63 | 135.25 | 19.34 ± 1.05 | 19.58 | 19.34 | 48.35 ± 1.39 | 49.24 | 48.35 | 51.45 ± 1.24 | 52.28 | 51.41 | 12.22 ± 0.88 | 12.56 | 13.07 |
| 16 | 40 | 12 | 80 | 150.45 ± 3.93 | 149.66 | 148.32 | 21.54 ± 0.45 | 21.64 | 21.54 | 53.64 ± 0.76 | 54.34 | 53.64 | 54.88 ± 1.03 | 55.29 | 54.84 | 12.42 ± 0.17 | 12.56 | 12.41 |
| 17 | 45 | 14 | 70 | 156.85 ± 0.83 | 157.58 | 156.91 | 21.64 ± 0.34 | 21.31 | 21.64 | 56.02 ± 0.75 | 55.35 | 55.66 | 57.26 ± 0.41 | 56.82 | 57.25 | 13.90 ± 0.18 | 13.70 | 13.90 |
| 18 | 55 | 10 | 90 | 155.77 ± 0.66 | 155.82 | 155.90 | 21.25 ± 1.16 | 21.02 | 21.25 | 55.63 ± 1.06 | 55.44 | 54.98 | 58.85 ± 0.52 | 58.13 | 58.71 | 12.86 ± 0.31 | 13.02 | 12.93 |
| 19 | 55 | 10 | 70 | 125.94 ± 2.29 | 126.75 | 127.34 | 15.27 ± 0.30 | 14.76 | 15.27 | 41.65 ± 0.57 | 40.58 | 43.27 | 44.42 ± 0.24 | 43.26 | 46.01 | 9.85 ± 0.52 | 9.71 | 9.85 |
| 20 | 50 | 12 | 80 | 160.14 ± 1.56 | 160.08 | 160.36 | 17.85 ± 0.89 | 17.88 | 17.85 | 44.63 ± 0.71 | 45.08 | 44.63 | 46.70 ± 0.81 | 46.88 | 46.71 | 10.31 ± 0.25 | 10.46 | 10.31 |
| Predictive capacity comparison of RSM and ANN models for five response variables | R2 | 0.99 | 0.99 | 0.99 | 1.00 | 0.98 | 0.99 | 0.99 | 0.99 | 0.97 | 0.97 | |||||||
| RMSE | 0.28 | 0.63 | 0.22 | 0.00 | 0.67 | 0.40 | 0.54 | 0.15 | 0.19 | 0.19 | ||||||||
| AAD (%) | 0.24 | 0.24 | 0.79 | 0.01 | 1.19 | 0.29 | 1.19 | 0.29 | 0.23 | 0.12 | ||||||||
| TS-POJ | 44 | 13 | 68 | 156.85 | 22.51 | 57.50 | 59.05 | 14.38 | ||||||||||
| C-POJ | 147.22 | 19.64 | 54.68 | 55.84 | 15.77 | |||||||||||||
| P-POJ | 142.86 | 17.78 | 52.33 | 53.35 | 12.86 | |||||||||||||
| Bacteria | Inhibition Zone Diameter (Mean ± SD, mm) | ||||||||
|---|---|---|---|---|---|---|---|---|---|
| C-POJ | P-POJ | TS-POJ | |||||||
| %100 | %50 | CN | %100 | %50 | CN | %100 | %50 | CN | |
| Escherichia coli | 7.11 ± 0.08 | ND | 22.04 ± 1.05 | 7.02 ± 0.19 | ND | 23.00 ± 0.12 | 7.00 ± 0.20 | ND | 20.97 ± 0.45 |
| Proteus vulgaris | 10.00 ± 0.20 | 6.98 ± 0.13 | 21.74 ± 0.54 | 9.14 ± 0.13 | 7.13 ± 0.12 | 21.03 ± 0.15 | 9.00 ± 0.12 | ND | 21.95 ± 0.19 |
| Pseudomonas aeruginosa | 9.00 ± 0.12 | ND | 21.96 ± 0.2 | 8.03 ± 0.10 | ND | 21.02 ± 0.28 | 8.07 ± 0.50 | ND | 22.00 ± 0.06 |
| Bacillus cereus | 7.18 ± 0.21 | ND | 22.27 ± 0.51 | 7.11 ± 0.21 | ND | 21.67 ± 0.71 | 8.00 ± 0.12 | ND | 22.87 ± 0.37 |
| Staphylococcus aureus | 7.98 ± 0.53 | ND | 21.80 ± 0.30 | 8.05 ± 0.24 | ND | 23.00 ± 0.50 | 8.00 ± 0.12 | ND | 22.00 ± 0.60 |
| Enterococcus faecalis | 7.08 ± 0.17 | ND | 17.00 ± 0.15 | 6.91 ± 0.28 | ND | 17.03 ± 0.08 | 9.48 ± 0.50 | 8.93 ± 0.08 | 18.62 ± 0.54 |
Disclaimer/Publisher’s Note: The statements, opinions and data contained in all publications are solely those of the individual author(s) and contributor(s) and not of MDPI and/or the editor(s). MDPI and/or the editor(s) disclaim responsibility for any injury to people or property resulting from any ideas, methods, instructions or products referred to in the content. |
© 2024 by the authors. Licensee MDPI, Basel, Switzerland. This article is an open access article distributed under the terms and conditions of the Creative Commons Attribution (CC BY) license (https://creativecommons.org/licenses/by/4.0/).
Share and Cite
Yıkmış, S.; Erdal, B.; Doguer, C.; Levent, O.; Türkol, M.; Tokatlı Demirok, N. Thermosonication Processing of Purple Onion Juice (Allium cepa L.): Anticancer, Antibacterial, Antihypertensive, and Antidiabetic Effects. Processes 2024, 12, 517. https://doi.org/10.3390/pr12030517
Yıkmış S, Erdal B, Doguer C, Levent O, Türkol M, Tokatlı Demirok N. Thermosonication Processing of Purple Onion Juice (Allium cepa L.): Anticancer, Antibacterial, Antihypertensive, and Antidiabetic Effects. Processes. 2024; 12(3):517. https://doi.org/10.3390/pr12030517
Chicago/Turabian StyleYıkmış, Seydi, Berna Erdal, Caglar Doguer, Okan Levent, Melikenur Türkol, and Nazan Tokatlı Demirok. 2024. "Thermosonication Processing of Purple Onion Juice (Allium cepa L.): Anticancer, Antibacterial, Antihypertensive, and Antidiabetic Effects" Processes 12, no. 3: 517. https://doi.org/10.3390/pr12030517
APA StyleYıkmış, S., Erdal, B., Doguer, C., Levent, O., Türkol, M., & Tokatlı Demirok, N. (2024). Thermosonication Processing of Purple Onion Juice (Allium cepa L.): Anticancer, Antibacterial, Antihypertensive, and Antidiabetic Effects. Processes, 12(3), 517. https://doi.org/10.3390/pr12030517

